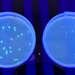
image.title

-
Biotechnologie Einführungslabor
© Hochschule Offenburg
-
Biotechnologie Einführungslabor
© Hochschule Offenburg
-
Biotechnologie Einführungslabor
© Hochschule Offenburg
-
Grün fluoreszierendes Protein einkloniert in E. col
© HS Offenburg

© Hochschule Offenburg

© Hochschule Offenburg

© Hochschule Offenburg
© HS Offenburg